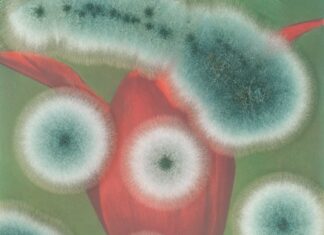
Ausstellung: TOUCH NATURE / Kulturforum New York

Ausstellung: TOUCH NATURE / Kulturforum New York
5. Oktober 2023 – 25. Februar 2024
TOUCH NATURE ist der Titel der neuen Ausstellung in der Galerie des Österreichischen Kulturforums in New York. Die Eröffnung findet am 5. Oktober 2023 statt und wird von...
Ausstellung zu Klimagerechtigkeit „Weather Engines“ / Kulturforum Madrid
Von 6. Oktober bis 25. Mai 2024
Die internationale Gruppenausstellung „Weather Engines“ („Klimamotoren“), die am 6. Oktober 2023 in Gijón (Asturien), im Rahmen der spanischen EU-Ratspräsidentschaft eröffnet wird, legt den Fokus auf Klimagerechtigkeit: Kunstwerke im...
Speak Dating / Generalkonsulat Hongkong
26. September
Das Speak-Dating Event, welches in Hongkong bereits zum zehnten Mal stattfinden wird, feiert jährlichen den Europäischen Tag der Sprachen. Es soll dazu beitragen, durch Fremdsprachenkenntnisse, kulturelle Barrieren zu überwinden und die Tür zu...
100 Ideas for the Western Balkans / Kulturforum Berlin
05. Oktober 2023
Architektur und Stadtplanung stehen weltweit zunehmend vor der Aufgabe, spezifische Lösungen für herausfordernde Anforderungen wie Sicherheit, Versorgung, Migration, Teilhabe und die Wiederherstellung von Lebensräumen und Komfort zu entwickeln und umzusetzen. Das Nachdenken...
Metal Urges – Ultima Festival / Botschaft Oslo
14.09.2023
Das Eröffnungskonzert „Metal Urges“ des diesjährigen Ultima Oslo Contemporary Music Festivals am 14.09.2023 bot eine ganz besondere genreübergreifende Weltpremiere - das Metal-inspirierte Stück "Epogdoon" des österreichischen Komponisten Bernhard Gander, gespielt von Oslo Sinfonietta und...
GÖTEBORGER BUCHMESSE / Botschaft Stockholm
28. September bis 1.Oktober
Die ÖB Stockholm nimmt am Stand des Kulturnetzwerks EUNIC CAFÉ EUROPA teil, der mit dem wohlbekannten Hintergrund des Wiener Café Central 10 Jahre an der Buchmesse Göteborg feiert.
Der Autor und Historiker...
Österreichische Literatur beim Budapester Internationalen Buchfestival / Kulturforum Budapest
28. September – 1. Oktober 2023
Das Österreichische Kulturforum ist gemeinsam mit dem Goethe Institut und der Schweizer Botschaft auf dem Internationalen Buchfestival mit dem deutschsprachigen Bücherstand DRUCKFRISCH vertreten. Neben der Präsentation der neuesten literarischen...
Europäischer Sprachentag 2023 / Botschaft Chisinau
26. September 2023
Am 26. September 2023 wird der Europäische Sprachentag, eine Initiative des Europarates, in der Republik Moldau gefeiert. Die Veranstaltung findet in der Nationalbibliothek in Chișinău statt und wird gemeinschaftlich von der Nationalbibliothek,...
Kunstausstellung in Sofia und Ruse / Botschaft Sofia
14. September - 4. Oktober Sofia
6. - 27. Oktober Ruse
Sechzehn österreichische und bulgarische Künstler:innen des kunstraumarkade in Mödling präsentieren die Ausstellung „Natural Space“ in Sofia und Ruse. Die Ausstellung ist Teil einer Reihe von...
Women in Journalism / Kulturforum London
12. Oktober 2023
InKooperation mit dem Weidenfeld Institute der Universität Sussex wird eine Lecture-Series zu Ehren der erfolgreichen Journalistin, Autorin und Zeitzeugin Hella Pick entwickelt. Die erste Diskussionsrunde der Vortragsreihe trägt den Titel „Women in...